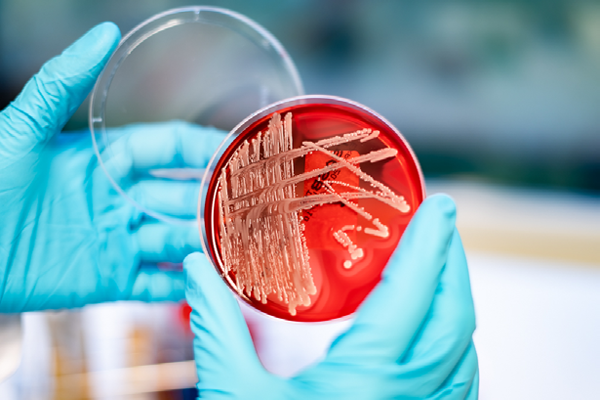

Clostridium botulinum

Clostridium botulinum er en stavformet, gram-positiv, sporedannende bakterie som tilhører slekten Clostridier og er vanlig å finne i jord, sjøsedimenter og tarmkanalen hos fisk og andre dyr. Selve bakterien er ufarlig for voksne. Det er nemlig toksinet som denne bakterien produserer som gjør oss syke og forårsaker botulisme hos mennesker. De første rapporter om botulisme går så langt tilbake som til 1793 og beskriver at forgiftningen ble assosiert med at personene spiste pølse. Derav kommer også artsnavnet lat. botulus = pølse.
Det skilles i dag mellom tre ulike typer botulisme: næringsmiddeloverført botulisme, spedbarnsbotulisme og sårbotulisme.
Hvilken produkter er bakterien knyttet til
Matbåren botulisme er en svært alvorlig intoksikasjon som oppstår ved inntak av næringsmidler som inneholder toksiner fra C. botulinum. Matvarer som ofte assosieres med botulisme er hjemmeprodusert rakfisk og spekemat, men bakterien kan også finnes i hjemmehermetiserte frukt- og grønnsaksprodukter. Siden botulinumtoksinet relativt lett inaktiveres av varme er det spesielt produkter som spises uten forutgående varmebehandling som er utsatt. Spedbarn kan bli smittet gjennom inntak av sporer i maten, særlig honning. Grunnet en manglende etablering av konkurrerende mikroflora i tarmen hos spedbarn kan sporene germinere og starte å vokse i tarmen med påfølgende toksinproduksjon.
Påvisning
Clostridier i næringsmidler påvises på vekstmediet, f.eks med NMKL 56. Ved mistanke om C. botulinum kan isolater funnet med NMKL 56, undersøkes videre ved hjelp av MALDI-TOF MS eller annen metode for artsidentifikasjon.
Reservoar
C. botulinum og dets sporer er vanlig i jord, sjøsedimenter og tarmkanalen hos fisk og andre dyr, og kan derfra smitte over på de fleste typer råvarer.
Vekstvilkår
Det finnes fire ulike grupper innen arten C. botulinum som tilsammen produserer 7 serologisk ulike neurotoksiner (A-G). De viktigste gruppene av C. botulinum som gir sykdom hos menneske er gruppe I (proteolytiske) og gruppe II (ikke-proteolytiske) som henspeiler på om det er behov for aktivering av toksinet med trypsin eller ikke. Disse to gruppene utviser forholdsvis stor forskjell når det kommer til veksttemperatur og sporenes varmeresistens. Mens C. botulinum i gruppe I har krav om minimum 10°C, pH 4,6 og aw >0,94 for vekst, kan C. botulinum i gruppe II vokse helt ned i 3,3°C, pH 5 og aw >0,97. Optimal veksttemperatur ligger noe høyere for gruppe I (35-40°C) enn gruppe II (18-25°C). C botulinum i gruppe I produserer også mer varmeresistente sporer enn C. botulinum i gruppe II.
Viktighet i Norge
Botulisme er en sjelden sykdom både i Norge og resten av verden. De siste 20 år er det meldt om 49 tilfeller i Norge. To større utbrudd i 2013 og 2015, med henholdsvis 7 og 10 tilfeller av botulisme, skyldtes sårbotulisme blant personer som tar stoff med sprøyter. Siden 1934 er det kun rapportert 5 dødsfall forårsaket av botulisme.
|
2012 |
2013 |
2014 |
2015 |
2016 |
2017 |
2018 |
2019 |
2020 |
2021 |
2022 |
|
|
Totalt |
0 |
8 |
4 |
13 |
1 |
2 |
1 |
1 |
2 |
0 |
0 |
Tabell 1: Antall tilfeller med botulisme 2012-2022 (Kilde: MSIS)
Symptomer og inkubasjonstid
Symptomer på sykdom inkluderer munntørrhet, øyelokkslammelse, dobbeltsyn, talebesvær, lammelser og forstoppelse. Dersom det ikke behandles kan alvorlige tilfeller av botulisme føre til død i løpet av 3-7 dager. Dødsfall skyldes som regel respirasjonssvikt.
Inkubasjonstiden ved næringsmiddeloverført botulisme er vanligvis 12-36 timer. Spedbarnsbotulisme har en noe lengre inkubasjonstid med 3 til 30 dager.
Forebygging
God hygiene når det lages rakfisk og spekemat er viktige forebyggende tiltak. Høyt saltinhold, lav lagringstemperatur, pH<4,6, konserveringsmidler og konkurrerende mikroflora vil også kunne hemme bakterievekst. I tillegg er det viktig med varmebehandling av mat for å ødelegge toksinet.
Ved produksjon av hermetikk er det helt avgjørende å inaktivere sporer ved hjelp av høy varme for å oppnå et trygt produkt. I hermetikkindustrien brukes D-verdien til gruppe I sporer (0,2 min ved 121°C) ved beregning av steriliseringsprosessen.
Honning skal ikke gis til spedbarn under 1 år.
Lovverket
Det er ikke noe krav i lovverket om prøvetaking av C. botulinum. Det forventes at næringsmiddelforetakene har gjennomført HACCP-analyse og dermed har kontroll på farene i sin produksjon.
Vi tilbyr
Eurofins Food & Feed Testing Norway AS utfører akkreditert analyse etter NMKL 56 for anaerobe sulfittreduserende bakterier og Clostridier i alle typer næringsmidler. Vi tilbyr også ulike metoder for artsbestemmelse som MALDI-TOF-MS, eller 16S rRNA-sekvensering. Ta kontakt med ditt lokale laboratorium for mer informasjon så hjelper vi deg gjerne videre.
Kilde: FHI, Mattilsynet
Les mer om bakterier →